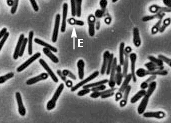

Endósporas y formas de persistencia
Introducción | Características microscópicas | Esporulación | Inducción | Propiedades | Germinación |
Viabilidad
|
Enlaces

Barra de exploración

Las endósporas bacterianas son formas de perdurabilidad de ciertos grupos de bacterias frente al calor, la desecación, la radiación y las influencias químicas. Contienen un genoma y toda la maquinaria metabólica esencial.
La termorresistencia de las endósporas es una de sus principales características. Mientras que las bacterias o las formas vegetativas de las bacterias esporuladoras sometidas a 80 ºC durante diez minutos (pasteurización) mueren, las endósporas sobreviven e incluso soportan un calentamiento
superior. Para eliminarlas son necesarias técnicas de
esterilización.
Esta característica permite un fácil método de aislamiento de las bacterias esporuladas, calentando el material donde se supone que existen
esporas a 100 ºC durante 10 minutos mueren todas las bacterias y, seguidamente,
las esporas sobrevivientes se hacen germinar y crecer en el
medio de cultivo adecuado.
Son formadoras de esporas las bacterias bacilares Gram positivas, entre ellas, las pertenecientes al genero Bacillus son aeróbicas y las del genero Clostridium anaeróbicas. Un aspecto interesante es que el
contenido de GC de este tipo de bacterias es bajo, los clostridios contienen la menor proporción de GC de los procariotas: 22 al 27 %.
Observadas con microscopía óptica muestran una gran refringencia. Esto es debido al elevado índice de refracción, resultante de las proteínas deshidratadas y concentradas en el pequeño espacio de la espora. Prácticamente toda la materia seca de la bacteria esta en la espora que posee un volumen igual a la décima parte de la bacteria que la origino. Se colorean en caliente con carlbolfucsina y no se decoloran cuando el frotis es lavado con etanol.
|
| E: endospora que da al conjunto aspecto de clava o masa |
Las bacterias formadoras de esporas se caracterizan por la
posición de la endoespora en la célula madre antes de ser liberada. La espora
pude ser central, terminal o subterminal, y la célula original puede o no
hincharse para acomodar la espora.

Tal como se observa en el esquema, la esporulación comprende:
 | una división asimétrica (1), durante la cual el futuro protoplasto de la espora recibe el material nuclear correspondiente. A diferencia de una
división común, el estrangulamiento del protoplasto de la célula materna no es seguido por el de la pared celular entre los dos protoplastos hijos (2).
|
 | a posteriori el protoplasto de la futura espora es rodeado por la membrana citoplasmática de la otra célula resultante de la división, siendo finalmente englobada por la misma (ver esquema).
|
 | el resultado de este englobamiento es que la futura espora esta rodeada por dos membranas citoplasmáticas que intervendrán en la fase final de la espora sintetizando
|
 | la membrana del protoplasto de la espora sintetiza hacia el exterior la pared celular
|
 | la membrana del protoplasto procedente de la otra célula sintetiza hacia el interior el cortex de la espora, compuesto de un glucopéptido similar a la
mureína pero con mayor cantidad de enlaces transversales.
|
 | esta otra célula forma en algunos casos el exosporio, que rodea a la espora como una envoltura suelta.
|
El material de las envolturas representa casi el 50% del peso seco de la espora madura.
El proceso someramente descrito es uno de los fenómenos de diferenciación
más complejos de la célula bacteriana. Entre las transformaciones químicas y físicas que acompañan a los cambios morfológicos destaquemos:
 | concentración del material proteico en la zona de formación de la espora
|
 | en razón de la concentración de material aumenta el índice de refracción de la zona
|
 | utilización del material de reserva (poli-beta-hidroxibutírico, en anaerobios y polisacáridos en aerobios) para procesos de degradación y síntesis
|
 | síntesis de ácido dipicolínico, especifico de las esporas, no se lo encuentra en las células vegetativas. Este ácido se combina en forma de quelato con iones
Ca++. Se localiza en el protoplasto de las esporas termorresistentes.
|
 | se liberan por autolisis de las células maternas
|
 | no presentan actividad metabólica
|
 | gran resistencia al efecto del calor
|
 | gran resistencia al efecto de las radiaciones
|
 | gran resistencia al efecto de los productos químicos
|
La resistencia a los efectos del calor se atribuye al bajo contenido de agua (aprox. 15%) y al contenido de ácido dipicolínico.
La resistencia al efecto de las radiaciones se atribuye a la presencia de puentes disulfuro, resultante de la presencia de cisteína en las proteínas de la cubierta externa.
La resistencia al efecto de los productos químicos debe atribuirse a la impermeabilidad que presenta en esos casos la cubierta de la espora.
En condiciones favorables los bacilos de las especies esporuladoras se reproducen indefinidamente en su forma vegetativa, la esporulación no es una fase obligada del ciclo de vida de la bacteria.
La formación de esporas se desencadena cuando faltan nutrientes o se acumula un exceso de productos del
metabolismo celular.
Puede inducirse la esporulación colocando las células en agua destilada, la cual se produce a expensas de las sustancias de reserva de la célula y, probablemente como consecuencia de la ausencia de sustrato en el medio. Avalando esta hipótesis, la formación de esporas no se produce si dentro de las cinco horas de puestas en agua destilada células vegetativas de Bacillus cereus, se agrega glucosa al medio.
La presencia de manganeso en el agua suele favorecer la esporulación.
El proceso por el cual las esporas pasan a formar células vegetativas se denomina germinación. Ocurre cuando se las coloca en el medio adecuado y se requiere en muchos casos la disponibilidad, entre otros, de glucosa, aminoácidos y nucleósidos. Es posible elevar el porcentaje de esporas que germinan con un
shock térmico.
Entre los fenómenos de la germinación destaquemos:
 | perdida de la resistencia térmica
|
 | aparición de la respiración
|
 | aparición de actividad enzimática
|
 | excreción de ácido dipicolínico, péptidos y aminoácidos
|
 | ruptura de las cubiertas y aparición del "tubo germinativo"(origen de la célula vegetativa)
|
A este punto
 | la pared celular de la célula emergente esta incompleta
|
 | la coloración de Gram por lo tanto no es la definitiva
|
 | hay permeabilidad a moléculas como el ADN (lo cual facilita fenómenos de
transformación)
|
Cuando se las almacena en tierra seca se ha demostrado que permanecen viables al cabo de 50 años el 10% de numero original.
Recientes hallazgos parecen indicar que
en ciertas arqueobacterias (Bacillus
sphaericus, Bacillus permians) bajo determinadas
condiciones (inclusión en ámbar o cristales salinos) la viabilidad de
las esporas es tan prolongada, que cabe la
posibilidad de plantearse que las mismas puedan sobrevivir indefinidamente.


Redacción y diagramación a cargo de: Dr. Jorge S. Raisman, lito@unne.edu.ar
Actualizado en Febrero del 2000. Reproducción autorizada únicamente con fines educativos
citando su origen. Se agradecen comentarios y sugerencias.
|